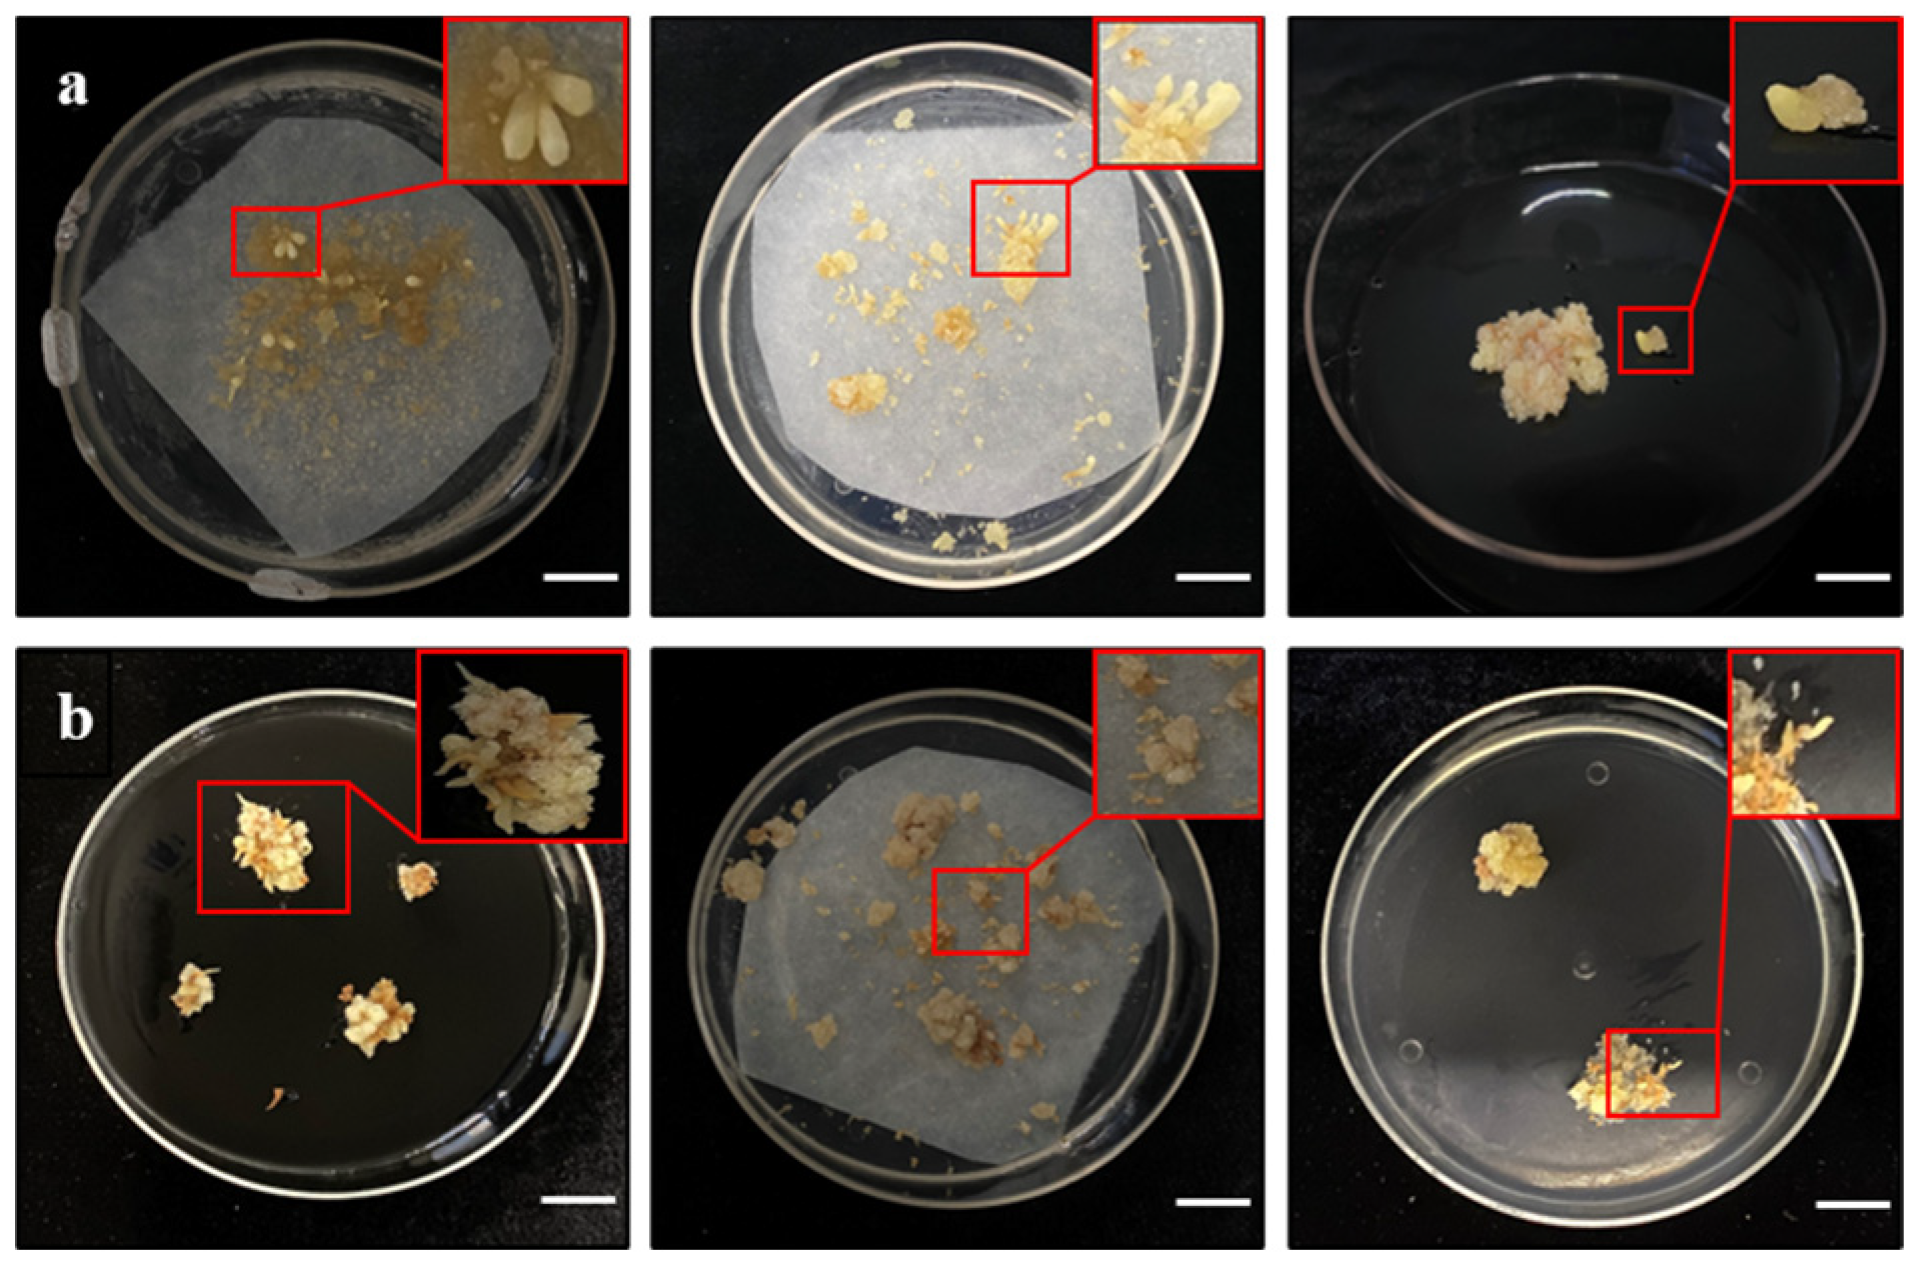
Forests 15 02058 g007 Forests 15 02058 g007

A Method for Genetic Transformation Using Embryonic Callus of Pinus koraiensis
Abstract
1. Introduction
2. Materials and Methods
2.1. Plant Material
2.2. Agrobacterium Strains
2.3. Antibiotic Sensitivity Test of Embryonic Callus
2.4. Agrobacterium Strain Culture
2.5. Genetic Transformation
2.6. GUS Histochemical Assay
2.7. PCR Analysis
2.8. Somatic Embryo Maturation
2.9. Statistical Analysis
3. Results
3.1. Cefotaxime Effects on Embryonic Callus
3.2. Kanamycin Effects on Embryonic Callus
3.3. Hygromycin Effects on Embryonic Callus
3.4. Effects of Infiltration Solution Concentrations
3.5. Effects of Co-Culture Cycle
3.6. Effects of Antibiotics on Callus Proliferation and Somatic Embryogenesis
3.7. GUS Staining of Resistant Tissues
3.8. PCR of Resistant Tissues
3.9. Effects of Gellan Gum on Somatic Embryo Maturation
4. Discussion
5. Conclusions
Supplementary Materials
Author Contributions
Funding
Data Availability Statement
Conflicts of Interest
References
- Zhang, Z.; Zhang, H.G.; Mo, C.; Zhang, L. Transcriptome Sequencing Analysis and Development of EST·SSR Markers for Pinus koraiensis. Sci. Silvae Sin. 2015, 51, 114–120. [Google Scholar]
- Yan, P.; Xie, Z.; Feng, K.; Qiu, X.; Zhang, L.; Zhang, H. Genetic diversity analysis and fingerprint construction of Korean pine (Pinus koraiensis) clonal seed orchard. Front. Plant Sci. 2023, 13, 1079571. [Google Scholar] [CrossRef] [PubMed]
- Wolff, R.L.; Pédrono, F.; Pasquier, E.; Marpeau, A.M. General characteristics of Pinus spp. seed fatty acid compositions, and importance of delta5-olefinic acids in the taxonomy and phylogeny of the genus. Lipids 2000, 35, 1–22. [Google Scholar] [CrossRef] [PubMed]
- Gao, F.; Peng, C.X.; Wang, H.; Tretyakova, I.N.; Nosov, A.M.; Shen, H.L.; Yang, L. Key Techniques for Somatic Embryogenesis and Plant Regeneration of Pinus koraiensis. Forests 2020, 11, 912. [Google Scholar] [CrossRef]
- Chen, S.G.; Qin, C.Y.; Wang, C.H.; Cai, J.F.; Tao, J. Study on Somatic Embryogenesis induction from immature seeds of five family lines of Pinus koraiensis. For. Eng. 2021, 37, 13–17. [Google Scholar] [CrossRef]
- Shen, X.; Jiang, X.; Yill, S.P.; Mahedrappa, M.K. Establishment of a technical system for somatic cell embryo culture of Pinus koraiensis. J. Chengdu Univ. 2005, 01, 11–14. [Google Scholar]
- Peng, C.X.; Gao, F.; Wang, H.; Shen, H.L.; Yang, L. Optimization of maturation process for somatic embryo production and cryopreservation of embryogenic tissue in Pinus koraiensis. Plant Cell Tissue Organ Cult. 2020, 144, 185–194. [Google Scholar] [CrossRef]
- Wang, G.; Fan, X.L.; Shen, X.H.; Sun, Y.L. Ultra-low temperature preservation of red pine embryonic healing tissue. J. Shanghai Jiao Tong Univ. 2009, 27, 223–225+230. [Google Scholar]
- Gao, F.; Shi, Y.J.; Wang, R.R.; Tretyakova, I.N.; Nosov, A.M.; Shen, H.L.; Yang, L. Exogenous Glutathione Promotes the Proliferation of Pinus koraiensis Embryonic Cells and the Synthesis of Glutathione and Ascorbic Acid. Plants 2022, 11, 2586. [Google Scholar] [CrossRef]
- Castander Olarieta, A.; Moncalean, P.; Montalban, I.A. Somatic Embryogenesis in Pines. Methods Mol. Biol. 2022, 25, 41–56. [Google Scholar] [CrossRef]
- Ramkumar, T.R.; Lenka, S.K.; Arya, S.S.; Bansal, K.C. A Short History and Perspectives on Plant Genetic Transformation. Methods Mol. Biol. 2020, 2124, 39–68. [Google Scholar] [CrossRef] [PubMed]
- Huang, Y.; Diner, A.M.; Karnosky, D.F. Agrobacterium rhizogenes-mediated genetic transformation and regeneration of a conifer: Larix decidua. In Vitro Cell. Dev. Biol.-Plant 1991, 27, 201–207. [Google Scholar] [CrossRef]
- Maruyama, T.E.; Hosoi, Y. Progress in Somatic Embryogenesis of Japanese Pines. Front. Plant Sci. 2019, 10, 31. [Google Scholar] [CrossRef]
- Dang, S.F.; Zhang, L.F.; Han, S.Y.; Qi, L.W. Agrobacterium-Mediated Genetic Transformation of Larix kaempferi (Lamb.) Carr. Embryogenic Cell Suspension Cultures and Expression Analysis of Exogenous Genes. Forests 2022, 13, 1436. [Google Scholar] [CrossRef]
- Tang, W. Agrobacterium-mediated transformation and assessment of factors influencing transgene expression in loblolly pine (Pinus taeda L.). Cell Res. 2001, 11, 237–243. [Google Scholar] [CrossRef][Green Version]
- Cui, Y.; Zhao, J.; Gao, Y.; Zhao, R.; Zhang, J.; Kong, L. Efficient Multi-Sites Genome Editing and Plant Regeneration via Somatic Embryogenesis in Picea glauca. Front. Plant Sci. 2021, 12, 751–891. [Google Scholar] [CrossRef]
- Hazubska-Przybyl, T.; Wawrzyniak, M.K.; Kijowska-Oberc, J.; Staszak, A.M.; RRatajczak, E. Somatic Embryogenesis of Norway Spruce and Scots Pine: Possibility of Application in Modern Forestry. Forests 2022, 13, 155. [Google Scholar] [CrossRef]
- Liang, Y.; Xu, X.; Shen, H.L.; Gao, M.L.; Zhao, Y.; Bai, X. Morphological and endogenous phytohormone changes during long-term embryogenic cultures in Korean pine. Plant Cell Tissue Organ Cult. 2022, 151, 253–264. [Google Scholar] [CrossRef]
- Gao, F.; Peng, C.X.; Wang, H.; Shen, H.L.; Yang, L. Selection of culture conditions for callus induction and proliferation by somatic embryogenesis of Pinus koraiensi. J. For. Res. 2021, 32, 483–491. [Google Scholar] [CrossRef]
- Peng, C.X.; Gao, F.; Wang, H.; Tretyakova, I.N.; Nosov, A.M.; Shen, H.L.; Yang, L. Suspension Culture and Somatic Embryogenesis of Korean pine. Phyton. Int. J. Exp. Bot. 2022, 91, 223–238. [Google Scholar] [CrossRef]
- Peng, C.X.; Gao, F.; Wang, H.; Shen, H.L.; Yang, L. Physiological and Biochemical Traits in Korean pine Somatic Embryogenesis. Forests 2020, 11, 577. [Google Scholar] [CrossRef]
- Wang, B.; Zhang, Z.; Yin, Z.; Feng, C.; Wang, Q. Novel and potential application of cryopreservation to plant genetic transformation. Biotechnol. Adv. 2011, 30, 604–612. [Google Scholar] [CrossRef] [PubMed]
- Yao, R.; Wang, Y. An advanced protocol for the establishment of plantlets originating from somatic embryos in Pinus massoniana. 3 Biotech 2020, 10, 394. [Google Scholar] [CrossRef] [PubMed]
- Zhang, Y. Establishment of Genetic Transformation Receptor Systems and Agrobacterium-Mediated Genetic Transformation in Three Coniferous Species. Ph.D. Thesis, Graduate School of Chinese Academy of Sciences, Shanghai, China, 2006. [Google Scholar]
- Maleki, S.S.; Mohammadi, K.; Ji, K.S. Study on factors influencing transformation efficiency in Pinus massoniana using Agrobacterium tumefaciens. Plant Cell Tissue Organ Cult. 2018, 133, 437–445. [Google Scholar] [CrossRef]
- Tang, W.; Xiao, B.; Fei, Y.J. Slash pine genetic transformation through embryo cocultivation with a tumefaciens and transgenic plant regeneratio. In Vitro Cell. Dev. Biol. Plant 2014, 50, 199–209. [Google Scholar] [CrossRef]
- Lin, X.; Zhang, W.; Takechi, K.; Takio, S.; Ono, K.; Takano, H. Stable genetic transformation of Larix gmelinii L. by particle bombardment of zygotic embryos. Plant Cell Rep. 2005, 24, 418–425. [Google Scholar] [CrossRef]
- Zhang, L.; Qi, L.W.; Han, S.Y. Differentially expressed genes during Larix somatic embryo maturation and the expression profile of partial genes. Yi Chuan Hered. 2009, 31, 540–545. [Google Scholar] [CrossRef]
- Tang, W.; Newton, R.J. Genetic transformation of conifers and its application in forest biotechnology. Plant Cell Rep. 2003, 22, 1–15. [Google Scholar] [CrossRef]
- Salaj, T.; Moravcikova, J.; Vookova, B.; Salaj, J. Agrobacterium-mediated transformation of embryogenic tissues of hybrid firs (Abies spp.) and regeneration of transgenic emblings. Biotechnol. Lett. 2009, 331, 647–652. [Google Scholar] [CrossRef]
- Le, V.Q.; Belles-Isles, J.; Dusabenyagasani, M.; Trembiay, F.M. An improved procedure for production of white spruce (Picea glauca) transgenic plants using Agrobacterium tumefaciens. J. Exp. Bot. 2001, 52, 2089–2095. [Google Scholar] [CrossRef]
- Liu, S.; Ma, J.; Liu, H.; Guo, Y.; Li, W.; Niu, S. An efficient system for Agrobacterium-mediated transient transformation in Pinus tabuliformis. Plant Methods 2020, 16, 52. [Google Scholar] [CrossRef] [PubMed]
- Gleeson, D.; Lelu-Walter, M.; Parkinson, M. Overproduction of proline in transgenic hybrid larch (Larix x leptoeuropaea (Dengler)) cultures renders them tolerant to cold, salt and frost. Mol. Breed. 2005, 15, 21–29. [Google Scholar] [CrossRef]
- Song, Y.; Bai, X.; Dong, S.; Yang, Y.; Dong, H.; Wang, N.; Zhang, H.; Li, S. Stable and Efficient Agrobacterium-Mediated Genetic Transformation of Larch Using Embryogenic Callus. Front. Plant Sci. 2020, 11, 584492. [Google Scholar] [CrossRef] [PubMed]

| Cef Concentration (mg·L−1) | Rate of Callus Proliferation (%) |
|---|---|
| 0 | 3.36 ± 0.32 a |
| 100 | 3.28 ± 0.49 a |
| 200 | 3.18 ± 0.43 a |
| 300 | 3.00 ± 0.39 a |
| 400 | 3.07 ± 0.75 a |
| 500 | 2.87 ± 0.42 a |
| Gellan Gum Concentration (g/L) | Amount of Somatic Embryogenesis (g·L−1) | |
|---|---|---|
| DCR Medium | mLV Medium | |
| 8 | 21.67 ± 4.41 a | 11.67 ± 4.16 a |
| 10 | 17.33 ± 6.03 a | 11.00 ± 4.35 a |
| 12 | 4.33 ± 1.53 b | 1.33 ± 1.53 b |
Disclaimer/Publisher’s Note: The statements, opinions and data contained in all publications are solely those of the individual author(s) and contributor(s) and not of MDPI and/or the editor(s). MDPI and/or the editor(s) disclaim responsibility for any injury to people or property resulting from any ideas, methods, instructions or products referred to in the content. |
© 2024 by the authors. Licensee MDPI, Basel, Switzerland. This article is an open access article distributed under the terms and conditions of the Creative Commons Attribution (CC BY) license (https://creativecommons.org/licenses/by/4.0/).
Share and Cite
Hou, H.; Wu, Y.; Yang, L.; Dong, H.; Zhao, W.; Shen, H.; Zhang, H.; Li, S. A Method for Genetic Transformation Using Embryonic Callus of Pinus koraiensis. Forests 2024, 15, 2058. https://doi.org/10.3390/f15122058
Hou H, Wu Y, Yang L, Dong H, Zhao W, Shen H, Zhang H, Li S. A Method for Genetic Transformation Using Embryonic Callus of Pinus koraiensis. Forests. 2024; 15(12):2058. https://doi.org/10.3390/f15122058
Chicago/Turabian StyleHou, Hui, Yanan Wu, Ling Yang, Hao Dong, Wenna Zhao, Hailong Shen, Hanguo Zhang, and Shujuan Li. 2024. "A Method for Genetic Transformation Using Embryonic Callus of Pinus koraiensis" Forests 15, no. 12: 2058. https://doi.org/10.3390/f15122058
APA StyleHou, H., Wu, Y., Yang, L., Dong, H., Zhao, W., Shen, H., Zhang, H., & Li, S. (2024). A Method for Genetic Transformation Using Embryonic Callus of Pinus koraiensis. Forests, 15(12), 2058. https://doi.org/10.3390/f15122058

